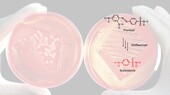
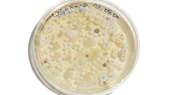
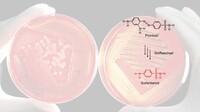
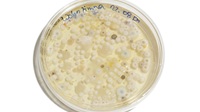

Infrarot-Spektroskopie
ISSN 2571-5860SCHWINGUNGSSPEKTROSKOPIE – Fingerabdruck der Moleküle, Teil 1: Infrarot-SpektroskopieBerzelius-Laborjournal, 6.02, 05/2025 (V01: 12/2022)
Vorwort
Dieses BLJ startet mit der Geschichte der Strukturlehre am Beispiel des blauen Jeans-Farbstoffs Indigo. Dann stellen wir die Vorteile von physikalischen Methoden in der Strukturaufklärung vor. Ein Exkurs zur elektromagnetischen Strahlung aus unserem Laborjournal «Photospektrometrie» dient als Einstieg ins Thema.
Die IR-Spektroskopie beruht darauf, dass die meisten Stoffe infrarotes Licht absorbieren. Am Beispiel von Wasser seht ihr, wie infrarotes Licht Molekülschwingungen anregt. Die Erde strahlt infrarotes Licht ab. Treibhausgase wie Wasserdampf oder Kohlendioxid absorbieren einen Teil dieser Wärme-strahlung. Dieses Phänomen beschreibt den natürlichen Treibhauseffekt, der Leben auf der Erde erst ermöglicht. Darüber hinaus geht es um die Folgen des anthropogenen, also vom Menschen verursachten, Treibhauseffekts.
Anhand von Filmen erklären wir die Messmethodik und lernen, das Spektrometer Alpha II der Firma Bruker zu bedienen. Anschliessend stellen wir einige Anwendungen dieser faszinierenden Technik vor. So unterscheiden wir zwischen illegalem THC- und legalem CBD-Hanf, überprüfen den Erfolg einer Synthese oder identifizieren Kunststoffe.
Inhalt

Folge zuerst den Hauptkapiteln in den linken Spalten, sonst überspringst du für das Verständnis wichtige Kapitel. Fahre mit dem Cursor auf die Bilder, um Hinweise zu erhalten.
In den Exkursen auf der rechten Seite findest du interdisziplinäre Zusammenhänge und Anwendungen.
Hauptkapitel ⇓ ; Exkurse ⟹
Die Anfänge der organischen Chemie
Schon im Jahre 1858 postulierte Kekulé:
- Kohlenstoffatome können sich zu Ketten in beliebiger Länge und Komplexität verbinden.
- Kohlenstoffatome sind immer 4-wertig, können also vier Bindungen eingehen.
- Die Zahl der einwertigen Bindungspartner an einer linearen Kohlenstoffkette mit n C-Atomen ist (2n + 2). Dies wird im Hintergrundbild exemplarisch an Kohlenwasserstoffen (Verbindungen nur aus C- und H-Atomen) gezeigt. So ist beispielsweise für n = 3, der Wert für 2n +2 =
8. Die Formel ist also C₃H₈
18 Jahre für eine einzige Strukturformel!

Adolf von Baeyer 18 Jahre zum Entschlüsseln der Strukturformel des natürlichen Farbstoffs Indigo C₁₆H₁₀O₂N₂ (blauer Jeans-Farbstoff). Je komplexer das Molekül, desto länger und mühsamer die Strukturaufklärung.
Heute hilft die Physik
Die instrumentelle Analytik vereinfachte die Struktur-aufklärung von Molekülen enorm. Diese physikalischen Methoden beruhen auf der Wechselwirkung von elektromagnetischer Strahlung mit den Molekülen der Materie. Aus der Energie der absorbierten Strahlung können Rückschlüsse auf die Struktur der untersuchten Moleküle gezogen werden. Die ältesten spektroskopischen Verfahren beruhen auf der Wechselwirkung von Stoffen mit sichtbarem Licht. Diese Interaktion ist stoffspezifisch. Erfolgt eine Absorption im sichtbaren (englisch visible, VIS ) oder ultravioletten (UV) Wellenlängenbereich des Spektrums, spricht man von UV/VIS-Spektroskopie. Wechselwirkungen mit Infrarot-Strahlung nennt man IR-Spektroskopie.
Mehr zum Indigo, den König der Farbstoffe, gibt es hier.
Durch Anklicken kannst du die Seiten aufrufen.
Elektromagnetische Strahlung
Mehr zu diesem Thema findest du im Exkurs zur elektromagnetischen Strahlung im Laborjournal zur
Photospektrometrie.
Schwingungen in Molekülen
Tanzende Moleküle
- Streck- oder Valenzschwingungen: Schwingungen in Richtung der Bindungsachse zweier Atome oder Molekülteile durch eine Dehnung oder Stauchung der Bindung. Diese kann symmetrisch oder asymmetrisch erfolgen.
- Deformationsschwingungen (Biege-/Beugeschwingungen): Schwingungen unter Deformieren des Bindungswinkels.
Absorption von infrarotem Licht
Die Schwingungen der Atome in einem Molekül lassen sich mit Schwingungen von Kugeln, die mit Federn verbunden sind, modellieren. Die Energie von infrarotem Licht reicht aus, um Bindungen zu verstärktem Schwingen (Strecken oder Verformen) anzuregen. Sie ist jedoch deutlich geringer als die Energie, die zum Spalten einer Atombindung benötigt wird.
Die absorbierten Frequenzen hängen von der Struktur des bestrahlten Moleküls ab und sind dessen spektroskopischer Fingerabdruck. So weisen Doppel- oder Dreifachbindungen im Allgemeinen eine höhere Bindungsenergie als Einfachbindungen auf, d. h. sie können anhand der absorbierten Frequenzen unterschieden werden.
Infrarot-Spektroskopie
Das Messprinzip
Fazit IR-Spektren
- In der Spektroskopie wird zwischen dem nahen Infrarot NIR (Wellenzahl 12500–4000 cm⁻¹; Wellenlänge 0.8– 2.5 µm), dem mittleren oder klassischen Infrarot MIR (Wellenzahl 4000–400 cm⁻¹; Wellenlänge 2.5–25 µm) und dem fernen Infrarot FIR (Wellenzahl 400–10 cm⁻¹; Wellenlänge 25–1000 µm) unterschieden.
- Die Wellenzahl ist der Kehrwert der Wellenlänge. Die Einheit ist cm⁻¹.
- Die Wellenzahl ist proportional zur Frequenz und zur Energie der Strahlung; die Skala ist linear.
- In IR-Spektren wird meistens die Transmission als Funktion der Wellenzahl aufgetragen.
- Die Transmission ist das Verhältnis der Intensitäten des absorbierten und eingestrahlten IR-Lichts. Die Angabe erfolgt in %.
- 100 % Transmission bedeutet, dass die Messprobe bei dieser Wellenzahl kein IR-Licht absorbiert, ein Wert von
0 % bedeutet, dass die Messprobe bei dieser Wellenzahl das gesamte Licht absorbiert.
- Das Alpha-II-Spektrometer misst im mittleren IR-Bereich. Der Berzelius-Gerätepark bietet auch ein im Nahinfrarotbereich messendes NIR-Spektrometer (NIR, near-infrared) zum Ausleihen.
Der IR-Fingerabdruck von Wasser
IR und Atmosphäre

Die elektromagnetische Strahlung, die von der Sonne ausgeht, umfasst unter anderem kurzwellige Strahlung wie Röntgen- oder UV-Strahlung. Diese wird weitgehend in der oberen Atmosphäre absorbiert. Erdoberfläche, Wolken und Atmosphäre reflektieren etwa 30 % der Strahlung zwischen 300 und 800 Nanometer in den Weltraum. Etwa 50 % der von der Sonne eintreffenden Energie wirken auf die Erdoberfläche und die unteren Atmosphärenschichten ein. Die auftreffende Strahlung erwärmt die Erde. Diese strahlt einen Teil der aufgenommenen Energie als längerwellige Infrarotstrahlung wieder ab.
Treibhausgase absorbieren infrarotes Licht.
Wasserdampf und Spurengase in der Atmosphäre wie Kohlendioxid, Ozon oder Methan absorbieren den grössten Teil der abgestrahlten Infrarotstrahlung. Die Folge ist eine Erwärmung der Atmosphäre: der natürliche Treibhauseffekt.
Wenn du mehr über Folgen und Ursachen der Klima-erwärmung wissen willst, klicke auf die nachstehenden Bilder.
Zurück zur IR-Spektroskopie: MessmethodeAttenuated Total Reflection (ATR)
Die ATR-Spektroskopie eignet sich für feste und flüssige Proben. Die Messprobe muss in einem möglichst engen Kontakt mit dem Diamanten sein. Bei Flüssigkeiten ist dies der Fall, feste Stoffe müssen mittels Stempel angedrückt werden, was ich auch in verschiedenen Videosequenzen beschreibe.
Mehr Informationen zur Totalreflexion erhältst du im Laborjournal zur Refraktometrie – Teil 1
Das IR-Spektrometer Alpha II
Auswerten von IR-Spektren
- Die Wellenzahl der Strahlung – und damit die Energie – zur Anregung einer Schwingung steigt mit der Bindungsstärke. Doppelbindungen weisen eine höhere Bindungsstärke als Einfachbindungen auf. So absorbieren C=C-Doppelbindungen IR-Strahlung bei höheren Wellen-zahlen, also höherer Energie als Einfachbindungen.
- Atomgruppen wie z. B. C=O-, O-H- oder C-C-Gruppen absorbieren IR-Strahlung in einem bestimmten Frequenz- bzw. Wellenzahlbereich. Der Bereich der funktionellen Gruppen liegt > 1500 cm ̄ ¹.
- Deformationsschwingungen werden meist bei niedrigeren Wellenzahlen (d. h. kleinerer Energiebedarf) angeregt als Streckschwingungen. Der Bereich von Wellenzahlen < 1500 cm ̄ ¹ heisst Fingerprintbereich. Dieser Bereich ist charakteristisch für Stoffe und dient zu deren Identifizierung.
Schlüsselbanden
Hinweis: Ar steht für aromatische Ringe wie Benzol.
Lust auf ein Quiz? Dann prüfe dein Wissen hier.
Die Fingerprint-Region liegt zwischen den Wellenzahlen 700 und 1500 cm ̄ ¹. In diesem Bereich befinden sich meist viele Banden, die nicht einzelnen Bindungen zugeordnet werden können. Sie entstehen durch Überlagerung von Streck- und Deformationsschwingungen vor allem von Einfachbindungen. Daneben gibt es auch sogenannte Gerüstschwingungen. Die Schwingungen in diesem Bereich sind nicht charakteristisch für einzelne funktionelle Gruppen, sondern für das Molekül als Ganzes. Sie stellen quasi einen Fingerabdruck dar. Stoffe können identifiziert werden, indem man ihr IR-Spektrum mit einer Datenbank von Spektren vergleicht.
Die Molekülschwingungen bestimmter Atomgruppen wie z. B. der Carbonylgruppe C=O liegen oberhalb einer Wellenzahl von 1500 cm ̄ ¹. Sie sind charakteristisch für Stoffe und eignen sich zur Bestimmung der funktionellen Gruppen von Molekülen. Typisch für Aceton ist die C=O-Streckschwingung bei einer Wellenzahl von 1715 cm ̄ ¹.
Bedienung des Alpha II
Anwendungen
Anwendungen der Infrarot-Spektroskopie

Maturaarbeiten

Einige Maturaarbeiten, bei denen die Infrarotspektroskopie zur Strukturaufklärung und Identifikation von Stoffen beigezogen wurde.
Berzelius-LaborjournalImpresssum
Editor-in-Chief und Projektleiter: Dr. Alfred Steinbach
Berzelius-Editorial-Team in alphabetischer Reihenfolge:
Dr. Adrian Brugger, Marianne Leuenberger, Patrick
Massen (Medienwerkstatt.PHSG), Dr. Martin Novotny, Markus Roth, Dr. Alfred Steinbach, Eva Steingruber, Dominik Tschirky.
Berzelius – Im Hightech-Labor der Naturwissenschaften ist ein gemeinsames Projekt des damaligen Instituts Fachdidaktik Naturwissenschaften (heute: Institut Mathematische, Naturwissenschaftliche und Technische Bildung) der PHSG und der Metrohm Stiftung.
Sulfanilamid – Ein Antibiotikum
Das Antibiotikum Sulfanilamid gehört zur Gruppe der Sulfonamide. Der deutsche Pathologe und Bakteriologe Gerhard Dogmagk (1895–1964) entdeckte dessen bakteriostatische Wirkung in den Dreissigerjahren des letzten Jahrhunderts. Sulfanilamid kann leicht in einem (Schul-)Labor synthetisiert werden.
Rechts sind die Strukturformel und das Kugel-Stab-Modell von Sulfanilamid dargestellt.
Synthese erfolgreich?
IR-Spektrum des Edukts
die typische Bande der C=O-Streckschwingung. Die Bande
bei ca. 3400 cm ̄ ¹ gehört zur N-H-Streckschwingung.
IR-Spektren von Edukt und Produkt

Falls du mehr über die Geschichte der Antibiotika wissen willst, klicke auf den Geldschein.
Geschichte der Antibiotika
Salvarsan
Sulfonamide
an sogenannten Azofarbstoffen*. Er stellte 1932 fest, dass das Sulfonamid Prontosil das Bakterienwachstum hemmte. Sulfonamide waren die ersten Breitspektrum-Antibiotika, die verschiedenste Bakterien erfassen. Sie wurden noch vor dem Penicillin eingesetzt. Dafür wurde Domagk 1939 der Nobelpreis verliehen. Er durfte diesen allerdings auf Druck des nationalsozialistischen Regimes nicht entgegennehmen. Nach dem Zusammenbruch des 3. Reiches wurde die Verleihung 1947 nachgeholt. Allerdings erhielt Domagk die dazugehörige Geldsumme nicht, da er diese nicht wie in den Stiftungsbestimmungen vorgesehen innerhalb eines Jahres entgegengenommen hatte. Domagks Tochter war die erste Patientin, welcher Prontosil erfolgreich verabreicht wurde. Sie litt an einer Blutvergiftung.
* Azofarbstoffe haben als Strukturmerkmal ein chromophores (farbgebendes) System aus einer Azo-Gruppe (-N=N-) und daran gebundenen Benzolringen. Die Azo-Gruppe ist im Prontosil rot markiert.
Prontosil
Ära der Sulfonamide
Sein etwas älterer Zeitgenosse Sir Alexander Fleming (1881 –1955), der «Vater» des Penicillins, fasste seine Leistung so zusammen: «Ohne Domagk keine Sulfonamide! Ohne Sulfonamide kein Penicillin! Ohne Penicillin keine Antibiotika.»
Quelle: Deutsche Apothekerzeitung 2010, Nr. 31
Wirkmechanismus der Sulfonamide
(4-Aminobenzoesäure ) dessen Bindungsstelle im aktiven Zentrum des Synthetase-Enzyms (kompetitive Hemmung). Die Inaktivierung dieses Enzyms blockiert die Synthese der Tetrahydrofolsäure, welche die Bakterien für die Produktion ihrer DNA benötigen. Deshalb wird das Bakterienwachstum gehemmt: bakteriostatische Wirkung.
Einsatz von Sulfonamiden
In der Veterinärmedizin sind Sulfonamide gängige Antibiotika, die bei Atemwegs-, Magen-Darm- und Harnwegserkrankungen eingesetzt werden. Des Weiteren sind sie oft Mittel der Wahl bei der Behandlung von Nagetieren, da diese im allgemeinen eine breite Unverträglichkeit auf Antibiotika (insbesondere Penicillin) aufweisen. Im Geflügelbereich waren Sulfonamide über lange Zeit das Mittel zur Bekämpfung von Kokzidien (Parasiten im Magen-Darm-Trakt).
PenicillinLebensretter Schimmelpilze
Das Interesse am Penicillin erlosch vorübergehend.
Strategische Bedeutung im zweiten Weltkrieg
Sorgloser Umgang
Zur Bekämpfung der Resistenz wurden Tausende von Derivaten des Penicillins auf halbsynthetische Weise hergestellt. So ist beispielsweise beim Penicillin G der Rest R ein aromatisches System.
Es entwickelte sich ein Wettlauf zwischen resistenten Bakterien und den Forschenden. Multiresistente Bakterien sind auf dem Vormarsch. Es gibt heute bereits «Superkeime», gegen die kein bekanntes Antibiotikum wirkt.
2019 starben weltweit etwa 1.3 Millionen Menschen, weil Antibiotika keine Wirkung mehr zeigten. Auch in der Schweiz führt die Antibiotikaresistenz pro Jahr zu etwa 300 Todesfällen.
Antibiotikaspritzen im Kuhstall80 Millionen Liter Milch pro Jahr unbrauchbar
Quelle: K-Tipp Nr. 8, 20. April 2022
Chemische Kriegsführung
Blockieren der Lactamase
Amoxicillin wird häufig zusammen mit Clavulansäure verabreicht. Diese wirkt nur sehr schwach antibakteriell, blockiert aber die Lactamase. Die Bakterien können Penicillin nicht mehr spalten, es ist wieder wirksam. Die Wirksamkeit hält allerdings nur so lange an, bis die Bakterien die Clavulansäure wieder chemisch so verändern können, dass sie die Lactamase nicht mehr blockieren kann. Dann sind solche Bakterien wieder resistent.
Herr K und das weisse Pulver
Strukturformeln
Die Strukturformeln von Kokain und Puderzucker unterscheiden sich deutlich. Suche in den beiden Strukturformeln die entscheidenden funktionellen Gruppen. Diese zeigen im IR-Spektrum jeweils charakteristische Banden, die zuvor erwähnten Schlüsselbanden. Erinnerst du dich? Falls nicht, kannst du hier deine Erinnerung in Sachen Schlüsselbanden auffrischen. Das IR-Spektrum des beschlagnahmten Pulvers ermöglicht somit eine fundierte Aussage, ob es sich bei besagtem Pulver um Puderzucker handelt oder nicht.
Puderzucker oder Kokain?
Kokain!
Schluss: Die Aussage, es handle sich beim weissen Pulver um Puderzucker, ist also falsch. Das Spektrum passt sehr gut zu Kokain. Der Vergleich mit dem Referenzspektrum von Kokain zeigt eine sehr gute Übereinstimmung.
Hanf (Cannabis)
Hanf (Cannabis)
- Seile (aus den Fasern der Stängel)
- Speiseöl (aus den Samen)
- ätherisches Öl (aus destillierten Blättern und Blüten)
- sowie Haschisch und Marihuana (aus getrockneten Blättern, Blüten und Blütenständen)
Cannabis war noch Ende des 19. Jahrhunderts in allen Apotheken als Medizinalpflanze für verschiedenste Indikationen im Angebot. Cannabis enthält mehr als 60 verschiedene Cannabinoide in unterschiedlichen Konzentrationen. Erst als Hanf als Rauschmittel zunehmende Bedeutung erlangte, wurde diese Pflanze verteufelt und schliesslich verboten. Inzwischen erfahren Cannabis und Cannabinoide (wichtigste Inhaltsstoffe von Hanf) eine Renaissance als Medizinalpflanze.
Tetrahydrocannabinol THC
Der Konsum von Cannabis mit einem THC-Gehalt von mindestens 1 % ist in der Schweiz grundsätzlich verboten. Seit 2013 kann der Konsum von Cannabis durch erwachsene Personen mit einer Ordnungsbusse von 100 CHF bestraft werden. Der Besitz von bis zu 10 Gramm Cannabis für den eigenen Konsum ist dagegen nicht strafbar.
Zu viel THC
Der Verband der Kantonschemiker*innen nahm Lebensmittel mit Cannabis oder Cannabisextrakten genauer unter die Lupe. Das Resultat war ernüchternd: Von 100 Proben mussten 85 beanstandet werden. Die Produkte wiesen in den meisten Fällen eine zu hohe Konzentration an psychoaktiven Tetrahydrocannabinol THC auf, oder die entsprechende Bewilligung für das verkaufte Produkt fehlte.
Quelle: Tagblatt 3.2.2022
Legale Hanfblüten?
Leitsubstanzen
Die eigentlichen Wirkstoffe CBD bzw. THC
bilden sich erst beim Rauchen oder Erhitzen .
CBD-Hanf?
Legaler CBD-Hanf!
Die Korrelation zur THCS-Referenz beträgt dagegen nur 49.1 %. Die IR-Spektroskopie ermöglicht eine eindeutige Zuordnung der Cannabis-Probe.
Der Film Drogen – So wirkt Cannabidiol aus Hanfpflanzen erklärt die berauschende Wirkung von THC.
Identifikation von Kunststoffen
Identifizieren von Kunststoffen
Kunststoffe wie Polyethylen (PE) und Polystyrol (PS) sind aus unserem Alltag nicht mehr wegzudenken. Äusserst funktional auf der einen Seite, abfalltechnisch bedenklich auf der anderen Seite. Viele sprechen vom Zeitalter des Kunststoffs, dem Material aus dem ein Grossteil unserer Gebrauchsstoffe besteht. Das Identifizieren von Kunststoffen spielt vor allem beim Recycling eine grosse Rolle. Nur sortenrein können Kunststoffe zu hochwertigen Produkten wiederverwertet werden. Die spektroskopischen Methoden spielen dabei eine wichtige Rolle. Online-Spektrometer, sogenannte Prozess-Spektrometer, die z. B. direkt am oder über dem Fliessband installiert sind, identifizieren den vorbeiziehenden Kunststoffabfall und garantieren die sortengemässe Trennung.
* Der Begriff Polymere stammt vom Namensgeber des Projekts, Jöns Jakob Berzelius. Es war das Jahr 1833, als er wieder Mal sein Talent für treffende Begriffe zeigte, auch wenn Polymere zu dieser Zeit für etwas anderes standen als heute. Man kannte gerade mal Cellulose, Naturkautschuk und dessen Vulkanisation mit Schwefel sowie einige andere Reaktionen, die zu Polymolekülen führten.
IR-Spektrum von Polyethylen
Polyethylen PE
verbunden werden. Der Einzelbaustein (das Monomer) ist Ethen (alter Name: Ethylen). Repetiereinheit oder Kettenausschnitt beschreiben den Aufbau von Kunststoffen. Der tiefgestellte Buchstabe «n» in der Repetiereinheit kann eine sehr grosse Zahl (bis 100'000) sein.
Hier mehr zur Polymerisation vom Simple-Club
Polyethylenterephthalat (PET)Neu entdecktes Enzym zersetzt PET-Kunststoff in Rekordzeit
Quelle: Neu entdecktes Enzym zersetzt PET-Kunststoff in Rekordzeit (chemie.de), abgerufen 18.5. 2022
Der Film «Plastic Planet» zeigt die dramatischen Auswirkungen unserer exzessiven Verwendung von Kunststoffen.
https://www.youtube.com/watch?v=jc5iJQ8mE6E
Charakterisierung von ätherischen Öle
Lavendelöl
Vergleich des Spektrums mit Lavendelöl aus der Datenbank
Die beiden Spektren (rotes Spektrum: gemessene
Kurve, schwarzes Spektrum: Lavendelöl aus der Datenbank) sind praktisch identisch. Dies äussert sich auch in einer Hitqualität von 994. Dieser Wert liegt nahe beim Maximum von 1000. Es handelt sich offensichtlich um Lavendelöl.
Die Übereinstimmung des gemessenen Spektrums mit dem Spektrum von Geraniumöl ist wesentlich schlechter. So beträgt die Hitqualität nur 436. Teste es selbst!
Inhaltsstoffe
Zur Herstellung werden die frischen Blüten der Lavendelpflanze einer Wasserdampfdestillation unterzogen. Die bekannteste Region zur Herstellung von qualitativ hochwertigen Lavendelölen ist Südfrankreich. Das meiste Lavendelöl kommt aus Nizza, Grasse, Monaco und Carpentras.
Medizinische Wirkung
Maturaarbeit Timo SchweizerParacetamolSynthese und Analyse
Timo Schweizer von der Kantonsschule Reussbühl in Luzern untersuchte 2021 in seiner Maturaarbeit die Synthese dieses Schmerzmittels. Als Edukte kamen 4-Aminophenol und Acetanhydrid zum Einsatz. Timo stellte dabei die klassische Methode unter Rückfluss der Mikrowellensynthese gegenüber. Die Ausbeute bei der Mikrowellensynthese war mit 41.6 % deutlich geringer als bei der klassischen Synthese mit 68.6 %. Den Erfolg der Synthese beurteilte er unter anderem mit der Infrarotspektroskopie.
IR-Spektrum von Paracetamol
Anhand der Schlüsselbanden kann der Erfolg der Synthese beurteilt werden. Die scharfe Bande bei ca. 3400 cm ̄ ¹ kann der N-H-Streckschwingung, die breite Bande bei ca. 3200 cm ̄ ¹ der O-H- und der C-H-Streckschwingung zugeordnet werden. Die Bande der C=O-Streckschwingung erscheint bei einer Wellenzahl von ca. 1650 cm ̄ ¹.
Algorithmen der Software vergleichen das Spektrum der gemessenen Substanz mit Referenzspektren der Datenbank. Die Hitqualität von 991 bei einem Maximum von 1000 zeigt, dass es sich beim Produkt um Paracetamol handelt.
Der Vergleich der IR-Spektren von Edukt und Produkt hätte es noch erlaubt, den Erfolg der Synthese anhand der C=O-Streckschwingung der Amidgruppe zusätzlich zu beurteilen.
In einem sehr aufschlussreichen Interview erzählt euch Timo Interessantes zu seiner tollen Arbeit. Empfehlenswert für alle, die sich für unsere Hightech-Geräte und eine Maturaarbeit interessieren.
Maturaarbeit Brando SchwarzenbachFruchtesterSynthese und Analyse
Brando Schwarzenbach von der Kantonschule Küsnacht im Kanton Zürich untersuchte 2023 in seiner Maturaarbeit die Synthese dieser Ester. Er verwendete verschiedene Methoden der Estersynthese und versuchte die Ausbeute zu optimieren. Mittels IR-Spektroskopie wies er die gebildeten Ester nach.
Infrarotspektrum von Buttersäuremethylester
Die Fingerprint-Region erlaubt die Identifikation von unbekannten organischen und anorganischen Stoffen. Algorithmen vergleichen das gemessene Spektrum mit Spektren aus der der Datenbank, entweder gekauft oder selbst auf Grundlage von Substanzstandards erstellt. Die Software berechnet einen Übereinstimmungswert für gemessenes und vorgeschlagenes Spektrum.
Eine schöne Erweiterung dieser Arbeit wäre der Vergleich mit den Raman-Spektren von Edukt und Produkt gewesen.
Maturaarbeit Sandro SchüsslerVerdural als Herznote für ParfumSynthese und Analyse
Sandro Schüssler von der Kantonsschule Alpenquai Luzern stellte 2024 in seiner Maturaarbeit ein Parfum mit dem selbst synthetisierten Blattduftstoff «Verdural» als Herznote her. Er veresterte dazu Essigsäure und (Z)-Hex-3-en-1-ol mittels Mikrowellensynthese. Diese weist gegenüber der klassischen Synthese mit längerem Rückflusskochen einige Vorteile wie eine Beschleunigung der Reaktionsgeschwindigkeit oder minimalen Energieverbrauch auf. Sandro verglich die säuren- und basenkatalysierte Synthese bezüglich Ausbeute und Qualität. Nach der Reinigung der Produkte erfolgte eine Qualitätsprüfung mit Hilfe von Dünnschichtchromatografie, Infrarot-, Raman- (https://creator.hosted-pageflow.com/revisions/688923#353435257) und ¹H-NMR-Spektroskopie.
IR-Spektrum von Verdural
Das säurekatalysierte Produkt war auch nach der Reinigung noch gelb gefärbt und die Übereinstimmung mit dem Spektrum des Reinstoffes etwas schlechter.
Maturaarbeit Justine BriodLavendelölHerstellung und Analyse von Lavendelöl
Justine Briod vom Gymnasium Renens (VD) absolvierte im Schuljahr 2022/23 ein Austauschjahr an der Kantonsschule Romanshorn. Sie verfasste eine Maturaarbeit in Chemie mit dem Thema: Gewinnung von Lavendelöl aus getrockneten und frischen Lavendelblüten. Sie untersuchte das durch Wasserdampfdestillation von Lavendelblüten isolierte Öl mittels Dünnschichtchromatografie und IR-Spektroskopie und verglich ihre Destillate mit handelsüblichem Lavendelöl. Zudem untersuchte sie den Einfluss von Lavendelöl auf eine stressvermindernde Wirkung vor Prüfungen.
Quantitative IR-MessungInfrarotspektren von Linalool, Linalylacetat und Lavendelöl
Diese Bande fehlt beim Alkohol Linalool. Gemäss dem Gesetz von Lambert-Beer besteht ein linearer Zusammenhang zwischen der Extinktion ( Absorption, Absorbanz) E und der Konzentration c eines Stoffes:
E = ε ∙ c ∙ d,
wobei ε der stoffspezifische Extinktionskoeffizient bei einer bestimmten Wellenzahl und d die Schichtdicke ist. Diese beiden Grössen sind bei einer bestimmten Wellenzahl konstant.
Reines Linalylacetat (97 %) zeigt bei einer Wellenzahl von 1741 cm ̄ ¹ eine Extinktion von 0.38, Lavendelöl 0.14 (rote Pfeile in den Spektren). Aus dem Verhältnis der beiden Extinktionen konnte Justine eine Konzentration von Linalylacetat im Lavendelöl von 36 % bestimmen. Die Literaturwerte liegen zwischen 25 und 46 %.
Treibhauseffekt
Die Treibhausgase
https://www.planet-schule.de/sf/embed.php?source=sendung:10117
Hinweis: K steht für Kelvin. Die Kelvin-Skala ist gegenüber der Celsius-Skala (°C) um 273.15 K verschoben. Eine Temperatur von 0 °C entspricht 273.15 K. Der absolute Nullpunkt liegt bei 0 K (= -273.15 °C). Der Zahlenwert eines Temperatur-unterschieds in den beiden Einheiten Kelvin und Grad Celsius ist gleich.
Der Mensch im AnthropozänAnthropogener Treibhauseffekt
Bill Gates spricht in seinem Buch Wie wir die Klimakatastrophe verhindern sogar von 51 Gigatonnen Kohlendioxid pro Jahr. Diese gewaltige Menge sollte die Menschheit auf Null reduzieren, um der Klimaerwärmung Einhalt zu gebieten.
Auf der Weltklimakonferenz 2022 in Ägypten warnte UN-Generalsekretär António Guterres in düsteren Worten vor den katastrophalen Folgen der Erderhitzung: «Wir sind auf dem Highway zur Klimahölle – mit dem Fuss auf dem Gaspedal». Mit Blick auf von der Klimakrise ausgelöste Dürren, Überschwemmungen, Unwetter und steigende Meeresspiegel warnte er, «Wir kämpfen den Kampf unseres Lebens – und sind dabei zu verlieren». Eindrücklicher konnte er die dramatische Situation des Klimas nicht beschreiben.
Kohlendioxid in der Atmosphäre
Durch Anklicken dieses Meteo-Schweiz-Links kannst du in einem interaktiven Film dein Wissen zum Thema Kohlendioxid auf Mauna Loa testen.
Über 30 Grad im Mai in der Schweiz
Wetter
Wettererscheinungen (zum Beispiel Niederschlag , Temperatur, Luftfeuchtigkeit, Windgeschwindigkeit und -richtung etc.) sind Zustände in der Atmosphäre, die wir direkt fühlen und miterleben können. Diese beziehen sich immer auf einen eher kurzen Zeitraum von Stunden, Tagen oder Wochen und werden für einen bestimmten Ort bzw. eine bestimmte Region angegeben.
Klima
Den Durchschnitt von Wettererscheinungen an einem bestimmten Ort, in einer Grossregion oder auch auf dem gesamten Globus über einen Zeitraum von mindestens 30 Jahren bezeichnet man als «Klima». Die Zeitspanne von 30 Jahren ist definiert als eine Klimanormalperiode. Das Klima ist wegen des grossen Zeitbereichs ein träges, stabileres System. Allfällige Veränderungen treten auf, sind aber wesentlich langsamer. Zudem ist der Schwankungsbereich deutlich kleiner. Das Klima wird dabei von vielen Faktoren bestimmt.
Quelle: myclimate_Klimabooklet_2020_CH
Suche nach blauen Farbstoffen
So entsteht Schmetterlingsblau nicht durch Reflexion des blauen Lichts oder Absorption der anderen Anteile des sichtbaren Lichts, sondern durch Brechung und Streuung des Lichtes an der Schüppchen-Struktur. Diese sind hoch geordnet und mikroskopisch klein. Dieses Phänomen wird als strukturelle Farbgebung bezeichnet.
Angesichts dieses Mangels an natürlichem Blau versuchten die Menschen schon früh, diese Farbe selbst herzustellen. Jüngste Funde aus einer Grabstätte in der Türkei lassen vermuten, dass das blaue Mineral Azurit vor 9000 Jahren zu einem feinen Pulver zermahlen wurde, vielleicht für kosmetische Zwecke. Die Ägypter mischten vor 5000 Jahren Sand, Pflanzenasche und Kupfer, um das erste synthetische blaue Pigment zu erzeugen. Im 19. Jahrhundert wetteiferten Chemiker darum, ein synthetisches Ultramarin herzustellen. So gab die BASF 18 Millionen Goldmark aus – mehr als das Unternehmen damals wert war –, um den tiefblauen Farbstoff Indigo zu synthetisieren. Dieses Blau wurde zu einem der gefragtesten Produkte der chemischen Industrie.
Blau aus gelbblühendem FärberwaidBlaue Kriegsbemalung
Geschichte der Blue Jeans
Küpenfärbung
Da Indigo in Wasser praktisch unlöslich ist, können Stoffe nicht direkt in einem wässrigen Färbebad eingefärbt werden. Durch Reduktionsmittel wird das Indigo in die wasserlösliche, gelbe Leukoform (reduzierte, fast farblose Form von Indigo) überführt. Die Änderung der Oxidationszahlen (in den Formeln mit römischen Zahlen aufgeführt) symbolisiert die Redoxreaktion. Dieses Färbebad heisst Küpe (lat. cupa: Tonne, Fass). In der reduzierten Form dringt Indigo gut in die Baumwollfaser ein und wird von den Fasern adsorbiert. Beim Trocknen an der Luft oxidiert Sauerstoff die Leukoform und der Farbstoff wird wieder blau.
Indigo zeichnet sich durch eine gute Waschechtheit aus. Allerdings ist der Farbstoff nicht abriebfest, sodass das Gewebe an beanspruchten Stellen sehr schnell verblasst. Dieser Effekt ist in der heutigen Mode durchaus erwünscht.
Synthese von Indigo
Die Vorteile des synthetischen Indigos gegenüber den pflanzlichen Rohstoffen sind evident:
- preisgünstiger
- farbkräftiger
- konstant hohe Qualität
- keine Ernteabhängigkeit
Patentschrift für Indigo
Blaumachen
Woher stammt der Begriff «Blaumachen»? Es gibt dafür ganz unterschiedliche Erklärungen. Die schönste ist sicher die von den Färbergesellen. Nach dem Färben mit Färberwaid mussten sie warten, bis die Tuche, die durch Oxidation erst mal gelb wurden, sich wieder blau färbten. Erst dann konnten sie weiterverarbeitet werden. Die Gesellen hätten sich die freie Wartezeit dann unter anderem mit Trinken vertrieben und so habe sich der «blaue Montag» herausgebildet.
Feiernde Gesellen am freien Montag im blauen Gewand
Der «gute Montag» ist ein noch älterer Ausdruck. Es handelt sich dabei um einen Tag, der den Gesellen von den Meistern zur Fortbildung zugestanden werden sollte, aber auch, um sich um eigene Dinge kümmern zu können. Viele Stadtobere behaupteten jedoch, die Gesellen hätten das ausgenutzt, um zu trinken und zu feiern, und sie haben so den Werktag zu einem Feiertag gemacht. Im Gegensatz zum braunen oder grauen Alltagskleid war die Farbe Blau die Feiertagskleidung.
Zum Anhören des folgenden Podcasts vom Südwestrundfunk zum Thema Blaumachen bitte den Ton einschalten und hier klicken.
Von Baeyer – Ein beliebtes Briefmarkenmotiv
Versäumnis der Deutschen Post
Im Jahr 1983 verpasste es die Deutsche Post, zu Ehren der 100-jährigen Strukturformel von Indigo eine Briefmarke herauszugeben. Kollegen der Universität Göttingen kreierten daraufhin eine «inoffizielle Marke» (vgl. «Briefmarke» rechts). Diese ist zwar nicht so wertvoll wie die blaue Mauritius, aber doch eine schöne Geste an Adolf von Baeyer.
Quelle: A Philatelic Ramble through Chemistry, E. Heilbronner/ F. A. Miller, Verlag Helvetica Chimica Acta 1998
Lapislazuli – Teures Blau ...
Es ist ein natürlich vorkommendes, tiefblaues metamorphes Gestein, welches je nach Fundort aus unterschiedlichen Anteilen der Minerale Lasurit (ein Natrium-Calcium-Alumosilicat), Pyrit (FeS₂), Calcit (CaO₃) sowie geringeren Beimengungen an Diopsid, Sodalith und anderen besteht.
Vermeers MeisterwerkDas Mädchen mit dem Perlenohrring (1665)
Zu den teuersten Farbkombinationen im Mittelalter gehörten Blau (das Kobaltblau des Lapislazulis) und das Rot (Kardinalsrot), das bis heute im Vatikan die Farbe der Erhabenheit und Würde darstellt.
Genug vom Blau! Kehren wir wieder zurück zum Kernthema, der Spektroskopie.
Starten der Software OPUS
Genaueres zu diesem Thema findest im Laborjournal zur Röntgenfluoreszenzspektroskopie unter dem Punkt:
Kalibrieren und Eichen.
Messen eines Kunststoffs
Messen von Flüssigkeiten
Messen von pulverförmigen Stoffen
Methanol – Der tödliche Bruder des Ethanols
Zeitungsmeldungen, in denen über tödliche Vergiftungen mit Methanol berichtet werden, sind leider keine Seltenheit. Meistens handelt es sich um unsachgemäss hergestellte Spirituosen, die grössere Mengen Methanol enthalten.
Giftcocktails oder nicht?
Äusserlich sieht man es diesen Spirituosen nicht an, ob sie Ethanol oder das viel giftigere Methanol enthalten. Auch vom Geschmack her, ist eine Unterscheidung kaum möglich.
Eine Möglichkeit des Panschens ist die Herstellung von Spirituosen mit im Vergleich zu Ethanol billigerem Methanol. Eine andere Form ist die illegale Beimischung von Methanol, um den Alkoholgehalt und die berauschende Wirkung des Getränks zu steigern.
Gepanscht oder echt?
Ethanol oder Methanol?
Raman-Spektren
Spektrum des «Flachmanns»
Gepanscht!
Methanol
Ethanol
Resorption von Alkohol
Abbau von AlkoholGiftige Stoffwechselprodukte
- Direkt nach Aufnahme von Methanol zeigt sich wie beim Ethanol ein narkotisches Stadium, die berauschende Wirkung ist jedoch geringer.
- Nach der häufig asymptomatischen Latenzphase treten Kopfschmerzen, Schwächegefühl, Übelkeit, Erbrechen, Schwindel, beschleunigte Atmung auf – die Folgen der sich ausbildenden metabolischen Acidose. Charakteristisch ist die Schädigung von Nerven, insbesondere am Auge. Netzhautödeme bedingen ein nur noch verschwommenes Sehen und können zur irreversiblen Erblindung führen.
- Zuletzt kann dann noch eine tödliche Atemlähmung auftreten.
Behandlung einer Methanol-Intoxikation
7.6 Liter reiner Alkohol ...
- 31.5 Liter Wein
- 1.6 Liter Obstwein,
- 52.8 Liter Bier
- 3.8 Liter Spirituosen
Umgerechnet in reinen Alkohol waren dies 7.6 Liter! Dies ist ein deutlicher Rückgang des Konsums alkoholischer Getränke verglichen mit 1900, als jeder Bewohner der Schweiz 16.5 Liter reinen Alkohol in einem Jahr konsumierte. Im Detail: 88.8 Liter Wein, 28.1 Liter Obstwein, 61.6 Liter Bier und 7.2 Liter Spirituosen.
Quelle: Eidgenössische Zollverwaltung
Atemalkohol im Strassenverkehr
Zur Messung: Zwei unterschiedliche und unabhängige Sensoren bestimmen die Konzentration des Alkohols in einer Atemprobe. Ein Infrarot-Sensor misst die Absorption von Ethanol in der Atemluft. Es handelt sich um eine physikalische Methode, während ein elektrochemischer Sensor chemische Reaktionen verwendet. Die Werte der beiden gemessenen Atemalkoholkonzentrationen müssen in engen Grenzen übereinstimmen.
Physiologie der Volksdroge Alkohol
Alkoholmissbrauch schädigt diverse Organe. Bei Alkoholismus werden vor allem Leber (Leberverfettung und Leberzirrhose) und Gehirn (Absterben von Neuronen) geschädigt.

SCHWINGUNGSSPEKTROSKOPIE – Fingerabdruck der Moleküle, Teil 1: Infrarot-Spektroskopie
SCHWINGUNGSSPEKTROSKOPIE – Fingerabdruck der Moleküle, Teil 1: Infrarot-Spektroskopie
 Vorwort
Vorwort
 Inhalt
Inhalt
 Die Anfänge der organischen Chemie
Die Anfänge der organischen Chemie
 18 Jahre für eine einzige Strukturformel!
18 Jahre für eine einzige Strukturformel!
 Elektromagnetische Strahlung
Elektromagnetische Strahlung
 Tanzende Moleküle
Tanzende Moleküle
 Absorption von infrarotem Licht
Absorption von infrarotem Licht
 Das Messprinzip
Das Messprinzip
 Fazit IR-Spektren
Fazit IR-Spektren
 Der IR-Fingerabdruck von Wasser
Der IR-Fingerabdruck von Wasser
 IR und Atmosphäre
IR und Atmosphäre
 Attenuated Total Reflection (ATR)
Attenuated Total Reflection (ATR)
 Das IR-Spektrometer Alpha II
Das IR-Spektrometer Alpha II
 Auswerten von IR-Spektren
Auswerten von IR-Spektren
 Fingerabdrücke von Molekülen
Fingerabdrücke von Molekülen
 Maturaarbeiten
Maturaarbeiten
 Impresssum
Impresssum
 Sulfanilamid – Ein Antibiotikum
Sulfanilamid – Ein Antibiotikum
 Synthese erfolgreich?
Synthese erfolgreich?
 IR-Spektrum des Edukts
IR-Spektrum des Edukts
 IR-Spektren von Edukt und Produkt
IR-Spektren von Edukt und Produkt
 Salvarsan
Salvarsan
 Sulfonamide
Sulfonamide
Prontosil
Prontosil
 Ära der Sulfonamide
Ära der Sulfonamide
 Wirkmechanismus der Sulfonamide
Wirkmechanismus der Sulfonamide
 Einsatz von Sulfonamiden
Einsatz von Sulfonamiden
 Penicillin
Penicillin
Strategische Bedeutung im zweiten Weltkrieg
Strategische Bedeutung im zweiten Weltkrieg
 Der dritte Mann
Der dritte Mann
 Sorgloser Umgang
Sorgloser Umgang
 Antibiotikaspritzen im Kuhstall
Antibiotikaspritzen im Kuhstall
 Chemische Kriegsführung
Chemische Kriegsführung
 Herr K und das weisse Pulver
Herr K und das weisse Pulver
 Strukturformeln
Strukturformeln
 Puderzucker oder Kokain?
Puderzucker oder Kokain?
 Kokain!
Kokain!
 Hanf (Cannabis)
Hanf (Cannabis)
 Tetrahydrocannabinol THC
Tetrahydrocannabinol THC
 Zu viel THC
Zu viel THC
 Legale Hanfblüten?
Legale Hanfblüten?
 Leitsubstanzen
Leitsubstanzen
 CBD-Hanf?
CBD-Hanf?
 Legaler CBD-Hanf!
Legaler CBD-Hanf!
 Identifizieren von Kunststoffen
Identifizieren von Kunststoffen
 IR-Spektrum von Polyethylen
IR-Spektrum von Polyethylen
 Polyethylen PE
Polyethylen PE
 Neu entdecktes Enzym zersetzt PET-Kunststoff in Rekordzeit
Neu entdecktes Enzym zersetzt PET-Kunststoff in Rekordzeit
 Charakterisierung von ätherischen Öle
Charakterisierung von ätherischen Öle
 Lavendelöl
Lavendelöl
 Vergleich des Spektrums mit Lavendelöl aus der Datenbank
Vergleich des Spektrums mit Lavendelöl aus der Datenbank
 Inhaltsstoffe
Inhaltsstoffe
 Medizinische Wirkung
Medizinische Wirkung
 Paracetamol
Paracetamol
 IR-Spektrum von Paracetamol
IR-Spektrum von Paracetamol
 Fruchtester
Fruchtester
 Infrarotspektrum von Buttersäuremethylester
Infrarotspektrum von Buttersäuremethylester
 Verdural als Herznote für Parfum
Verdural als Herznote für Parfum
 IR-Spektrum von Verdural
IR-Spektrum von Verdural
 Lavendelöl
Lavendelöl
 Quantitative IR-Messung
Quantitative IR-Messung
 Die Treibhausgase
Die Treibhausgase
 Anthropogener Treibhauseffekt
Anthropogener Treibhauseffekt
 Kohlendioxid in der Atmosphäre
Kohlendioxid in der Atmosphäre
 Gibt es den Aletschgletscher im Jahr 2100 noch?
Gibt es den Aletschgletscher im Jahr 2100 noch?
 Der Meeresspiegel steigt
Der Meeresspiegel steigt
 Über 30 Grad im Mai in der Schweiz
Über 30 Grad im Mai in der Schweiz
 Suche nach blauen Farbstoffen
Suche nach blauen Farbstoffen
 Blaue Kriegsbemalung
Blaue Kriegsbemalung
 Geschichte der Blue Jeans
Geschichte der Blue Jeans
 Küpenfärbung
Küpenfärbung
 Synthese von Indigo
Synthese von Indigo
 Patentschrift für Indigo
Patentschrift für Indigo
 Blaumachen
Blaumachen
 Bald blauer Schnee auf Schweizer Skipisten ...
Bald blauer Schnee auf Schweizer Skipisten ...
 Von Baeyer – Ein beliebtes Briefmarkenmotiv
Von Baeyer – Ein beliebtes Briefmarkenmotiv
 Lapislazuli – Teures Blau ...
Lapislazuli – Teures Blau ...
 Vermeers Meisterwerk
Vermeers Meisterwerk
 Starten der Software OPUS
Starten der Software OPUS
 Messen von pulverförmigen Stoffen
Messen von pulverförmigen Stoffen
 Methanol – Der tödliche Bruder des Ethanols
Methanol – Der tödliche Bruder des Ethanols
 Giftcocktails oder nicht?
Giftcocktails oder nicht?
 Gepanscht oder echt?
Gepanscht oder echt?
 Ethanol oder Methanol?
Ethanol oder Methanol?
 Raman-Spektren
Raman-Spektren
 Spektrum des «Flachmanns»
Spektrum des «Flachmanns»
 Gepanscht!
Gepanscht!
 Methanol
Methanol
 Ethanol
Ethanol
 Resorption von Alkohol
Resorption von Alkohol
 Abbau von Alkohol
Abbau von Alkohol
 Behandlung einer Methanol-Intoxikation
Behandlung einer Methanol-Intoxikation
 7.6 Liter reiner Alkohol ...
7.6 Liter reiner Alkohol ...
 Atemalkohol im Strassenverkehr
Atemalkohol im Strassenverkehr
 Physiologie der Volksdroge Alkohol
Physiologie der Volksdroge Alkohol